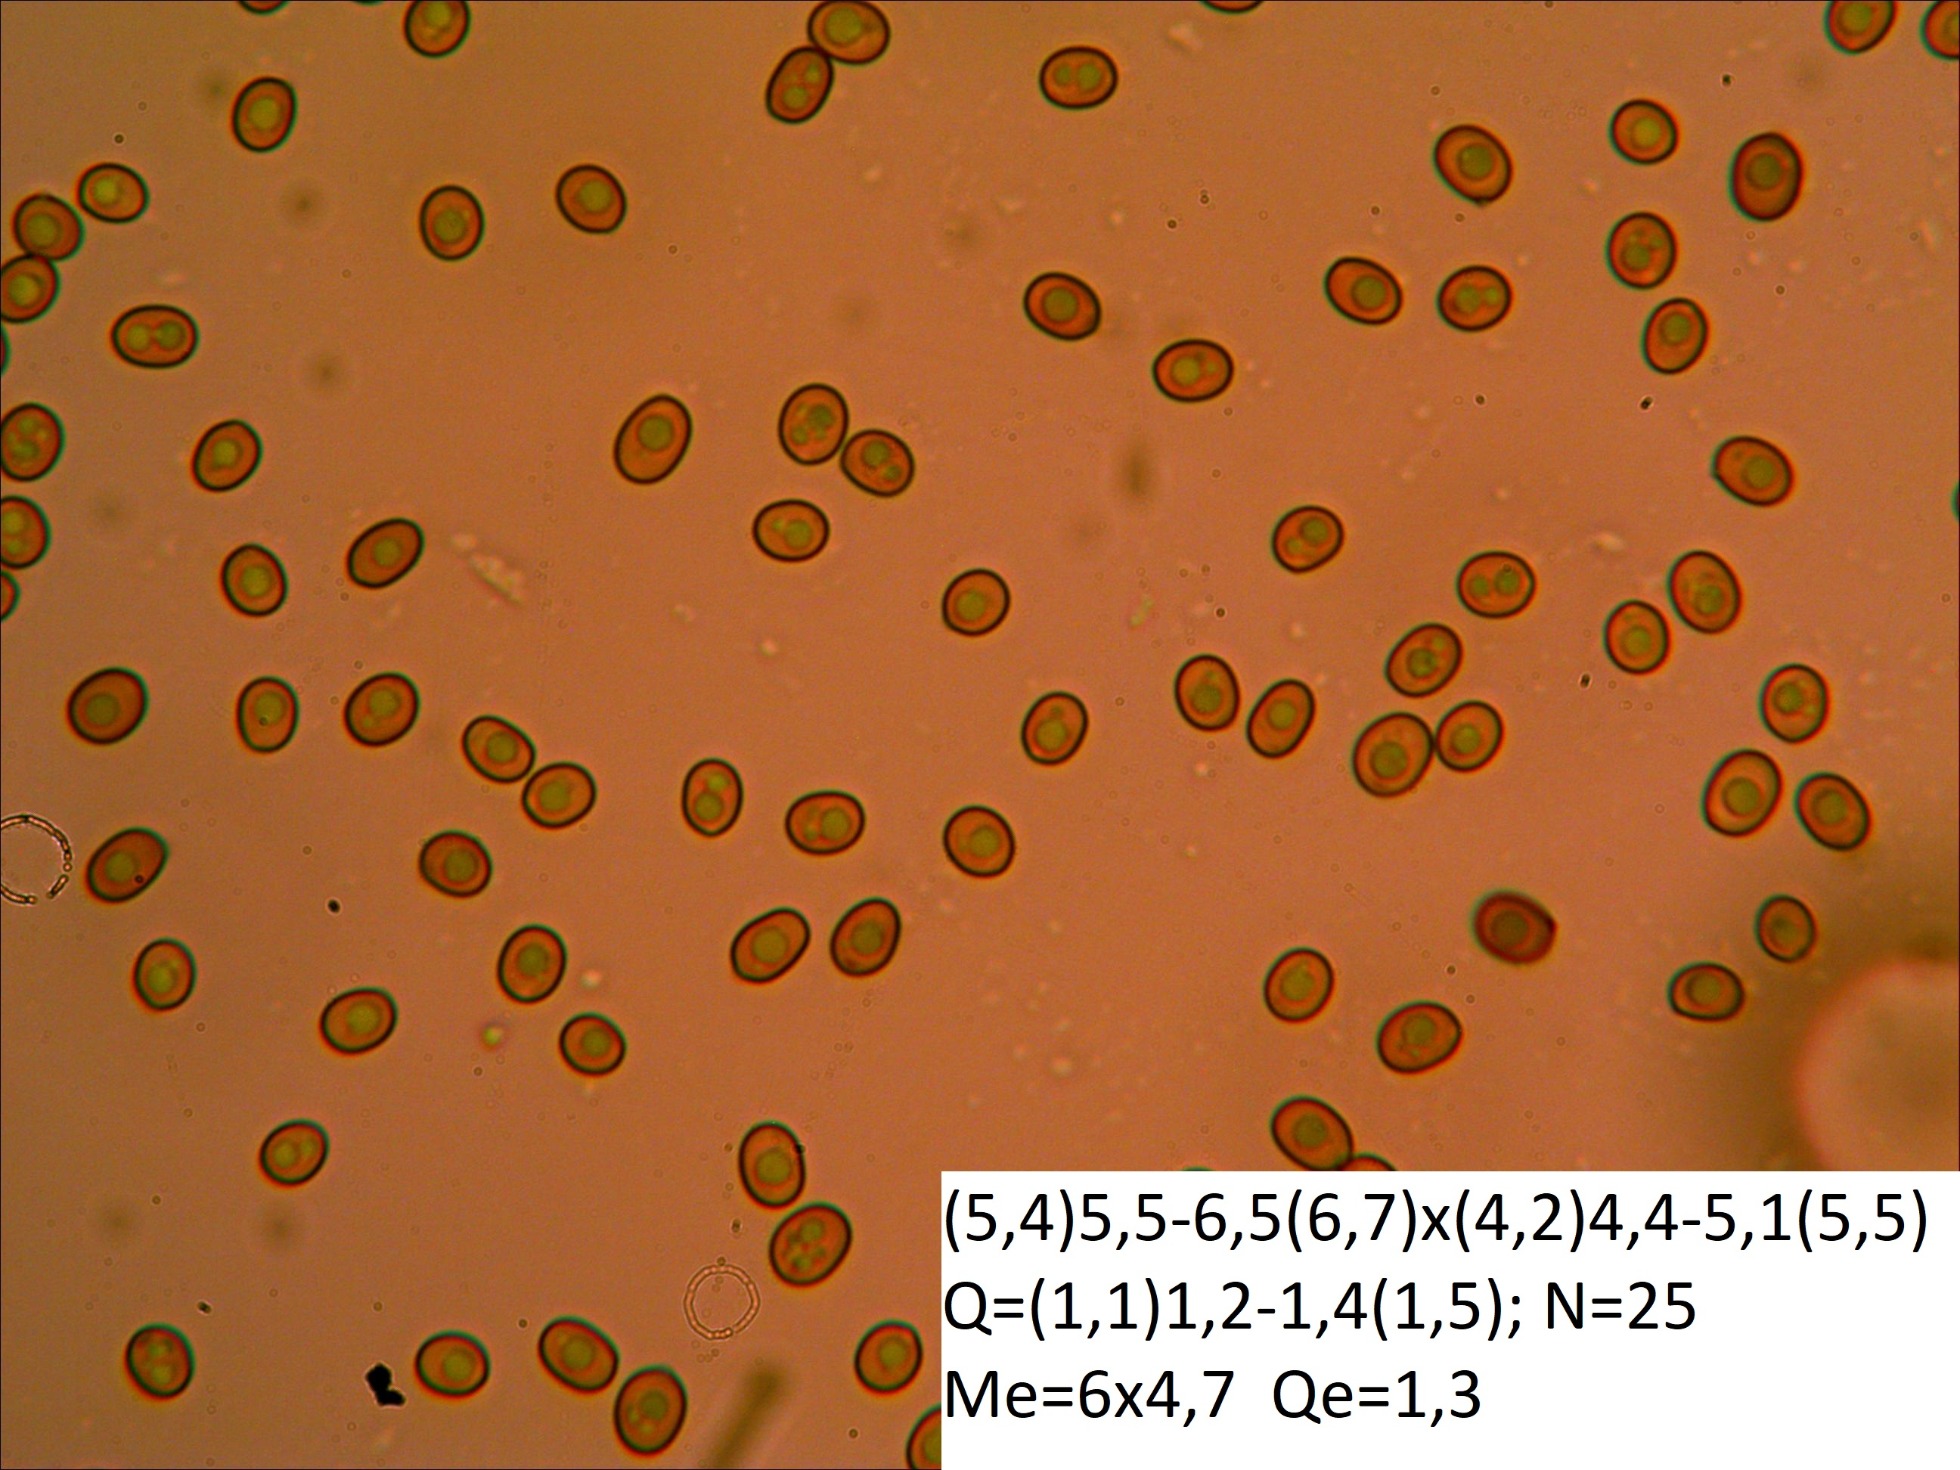

Agaricus devoniensis P.D. Orton 1960
Agaricus devoniensis P.D. Orton 1960
- Jon Joseba Arnedo
-
 Autor del tema
Autor del tema
- Fuera de línea
- Moderador
-

Menos
Más
- Mensajes: 3702
- Gracias recibidas: 3555
8 años 3 meses antes #97414
por Jon Joseba Arnedo
Agaricus devoniensis P.D. Orton 1960 Publicado por Jon Joseba Arnedo
Hola a tod@s
Sigo haciendo mis pinitos con el micro y en esta ocasión os presento una especie a la que tenía muchas ganas por lo específico de su hábitat, se trata de Agaricus devoniensis.
Localizado este pasado domingo 17 de diciembre en compañía de Javi, Juan y Ricardo en una zona dunar del litoral de Bizkaia.
Se trata de un Agaricus de tamaño medio, hasta 7-8 cm de diámetro, sombrero ligeramente fibrilloso y de color predominantemente blanco, aunque adquiriendo tonos pardos o grisáceos de adulto y que suele presentar restos de arena debido al hábitat en el que fructifica.
Pie corto, blanco y con un característico anillo ínfero a modo de calcetín.
Especie rara y a proteger debido a lo alterado que se encuentra su hábitat.
Agaricus devoniensis en su hábitat y ahora vamos con la microscopía.
Las esporas medidas en agua a 40x
Aquí el único basidio que pude observar y que parece bispórico. Aunque la bibliografía indique que suelen ser tetraspóricos, tengo constancia de recolectas bispóricas en esta misma zona.
Imágenes de la pileipellis, en esta caso, suprapellis, compuesta por hifas cilíndricas y septadas.
Un saludo
Sigo haciendo mis pinitos con el micro y en esta ocasión os presento una especie a la que tenía muchas ganas por lo específico de su hábitat, se trata de Agaricus devoniensis.
Localizado este pasado domingo 17 de diciembre en compañía de Javi, Juan y Ricardo en una zona dunar del litoral de Bizkaia.
Se trata de un Agaricus de tamaño medio, hasta 7-8 cm de diámetro, sombrero ligeramente fibrilloso y de color predominantemente blanco, aunque adquiriendo tonos pardos o grisáceos de adulto y que suele presentar restos de arena debido al hábitat en el que fructifica.
Pie corto, blanco y con un característico anillo ínfero a modo de calcetín.
Especie rara y a proteger debido a lo alterado que se encuentra su hábitat.
Agaricus devoniensis en su hábitat y ahora vamos con la microscopía.
Las esporas medidas en agua a 40x
Aquí el único basidio que pude observar y que parece bispórico. Aunque la bibliografía indique que suelen ser tetraspóricos, tengo constancia de recolectas bispóricas en esta misma zona.
Imágenes de la pileipellis, en esta caso, suprapellis, compuesta por hifas cilíndricas y septadas.
Un saludo
Por favor, Identificarse para unirse a la conversación.
- Josep Torres
-

- Fuera de línea
- Moderador
-

Menos
Más
- Mensajes: 8745
- Gracias recibidas: 8379
8 años 3 meses antes - 8 años 3 meses antes #97416
por Josep Torres
Respuesta de Josep Torres sobre el tema Agaricus devoniensis P.D. Orton 1960
Gracias Joseba, una especie muy interesante que desconocía, vas prosperando a pasos agigantados con la microscopía, mi más sincera enhorabuena  , solo un pequeño detalle del basidio que nos indicas bispórico, lo he observado detenidamente y a mí me parece claramente tetraspórico, sucede muy a menudo al realizar microscopías que en los basidios se observan solo dos esterigmas y moviendo solo un poco la regulación fina aparecen los otros dos en diferente plano y en el mismo basidio. He ampliado un poco tu imágen y te he señalado con un círculo lo que a mi modo de ver serían los 4 esterigmas.
, solo un pequeño detalle del basidio que nos indicas bispórico, lo he observado detenidamente y a mí me parece claramente tetraspórico, sucede muy a menudo al realizar microscopías que en los basidios se observan solo dos esterigmas y moviendo solo un poco la regulación fina aparecen los otros dos en diferente plano y en el mismo basidio. He ampliado un poco tu imágen y te he señalado con un círculo lo que a mi modo de ver serían los 4 esterigmas.
Un fuerte abrazo, campeón
Un fuerte abrazo, campeón
Última Edición: 8 años 3 meses antes por Josep Torres.
El siguiente usuario dijo gracias: Jon Joseba Arnedo
Por favor, Identificarse para unirse a la conversación.
- txelu
-

- Fuera de línea
- Moderador
-

Menos
Más
- Mensajes: 802
- Gracias recibidas: 621
8 años 3 meses antes #97419
por txelu
Respuesta de txelu sobre el tema Agaricus devoniensis P.D. Orton 1960
Aupa Joseba , una especie a tener en cuenta si nos acercamos por la costa .Ya veo que te estas metiendo en el fango de cabeza  , animarte para que sigas con el tema del micro , que tu puedes .Un saludo .
, animarte para que sigas con el tema del micro , que tu puedes .Un saludo .
El siguiente usuario dijo gracias: Jon Joseba Arnedo
Por favor, Identificarse para unirse a la conversación.
- Jon Joseba Arnedo
-
 Autor del tema
Autor del tema
- Fuera de línea
- Moderador
-

Menos
Más
- Mensajes: 3702
- Gracias recibidas: 3555
8 años 3 meses antes #97427
por Jon Joseba Arnedo
Respuesta de Jon Joseba Arnedo sobre el tema Agaricus devoniensis P.D. Orton 1960
Gracias Josep y Txelu!
Josep, muchas gracias por tomarte tu tiempo en mirar el basidio ampliado, cosa que ni yo mismo hice,jaja. Efectivamente ampliándolo se ve que es tetraspórico, cosa que en ningún momento descarté simplemente dije que me parecía bispórico porque incluso en la imagen a 100x no pude observar más que dos esterigmas.
simplemente dije que me parecía bispórico porque incluso en la imagen a 100x no pude observar más que dos esterigmas.
Aupa Txelu, aspaldiko! gracias por tus ánimos, a veces hacen falta aunque no es el caso, ya que sarna con gusto no pica
Un abrazo a ambos
Josep, muchas gracias por tomarte tu tiempo en mirar el basidio ampliado, cosa que ni yo mismo hice,jaja. Efectivamente ampliándolo se ve que es tetraspórico, cosa que en ningún momento descarté
Aupa Txelu, aspaldiko! gracias por tus ánimos, a veces hacen falta aunque no es el caso, ya que sarna con gusto no pica
Un abrazo a ambos
El siguiente usuario dijo gracias: Josep Torres
Por favor, Identificarse para unirse a la conversación.
- Héctor
-

- Fuera de línea
- Moderador
-

Menos
Más
- Mensajes: 1022
- Gracias recibidas: 1026
8 años 3 meses antes #97433
por Héctor
Respuesta de Héctor sobre el tema Agaricus devoniensis P.D. Orton 1960
Curiosa especie, la tenías entre ceja y ceja y al fin cayó. Ahora soy yo el que está picado 
El siguiente usuario dijo gracias: Jon Joseba Arnedo
Por favor, Identificarse para unirse a la conversación.
- Jon Joseba Arnedo
-
 Autor del tema
Autor del tema
- Fuera de línea
- Moderador
-

Menos
Más
- Mensajes: 3702
- Gracias recibidas: 3555
8 años 3 meses antes #97444
por Jon Joseba Arnedo
Respuesta de Jon Joseba Arnedo sobre el tema Agaricus devoniensis P.D. Orton 1960
jajaj, mira que la buscamos cuando viniste y ni rastro...ya la pillaras tu también 
Un abrazo
Un abrazo
Por favor, Identificarse para unirse a la conversación.
Tiempo de carga de la página: 0.114 segundos

Foro de micología